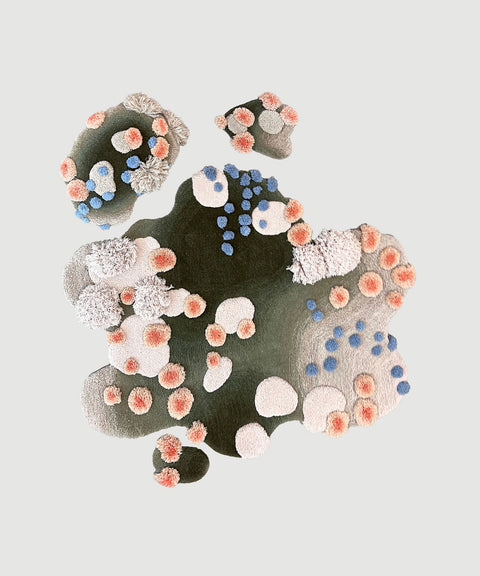

Swedish artist and designer Alfhild Külper, also known as Alfie’s Fuzzy Friends, is an emerging textile designer based in Amsterdam. Graduating from Central Saint Martins, the artist initially worked in fashion as a prominent head of design at Viktor&Rolf before pursuing full time her passion of creating hand-tufted textiles collectibles.
Through a conversation with the artist, we have an insight of her early interdisciplinary nature and the influences behind her transitive career as a creative. Initially, aiming to bring more softness to everyday life, her work navigates the complexities of human abstract memory and intuition, revealing an intimate journey of what it means to be human amidst the rising issues of climate change and societal stigmas of overconsumption. As a sustainable designer she embraces this by creating pieces with tangible and visual feelings that invite user to reconnect with nature as means to share the importance of the expansion of love and empathy within her immediate surroundings.

What is a purpose you deeply believe in?
There are several pillar stones that made me start this project. One of the really strong reasons, was a longing for a world that is more soft and much more organic, understanding and forgiving. I had just discovered in my own living space that everything felt so harsh, perfect and cornered, so this pilar came from a need for something that felt more human, soft and in tune with nature.
It is also a deep belief of mine that we need a counterpart to our digital lives, and even though it is fantastic the new endless possibilities given to us by technology, they sometimes are so ungraspable that I believe we need a tactile counterpart to sooth this. We look at so much imagery online that sometimes as humans we just crave touching things, which is why I really wanted to create something that really invites to that. Something that when you see it, you really want to just lay down on it. Giving this sensation of wanting to lean into it but also the possibility of grabbing and combing it as a form of stress relief from an increasingly fast paced world.

By creating art pieces that last a lifetime, what narrative would you like future generations to take from your work?
For me it is actually interesting because most of the pieces that I work with already come from this idea of a future weaved into them. My pieces are abstract memories of nature, which is the idea of taking what we love about the world as it is and how we remember, and using that to build a positive future out of it. So lets say, taking memories of a beautiful sunset or a beach that you have been too and then weaving them into a future where it is possible to create new resources and better living conditions by re-creating the natural environment as we once knew. It is taking the beauty of the world and giving ideas of what we can make our future living spaces look like. Hopefully that will also be something for the future generations to see. Maybe my pieces can suggest a direction for future generations to move towards—or maybe the world going onto a completely different direction, but these pieces will still be an idea of a possible utopia and a memory of where we are right now, which is such an interesting moment in time anyways.
The pieces are memories woven as stories. It can be my own stories or other people’s that I listen to. Right now, they have a lot to do with family and with love’s development as a concept. It is really interesting how love evolved through time— from the first recorded feelings of love between a parent and child, extending to spouses and pets, and most recently in history also to our friends. So that development is also something I am trying to convey in the pieces, in which I hope that it is something that will continue to grow and enable us to encompass the whole of humanity with it. So I really hope that future generations, when they see my pieces, that they can see where in history we were and where did we want to go.
what is the process behind the Angel Forever Swirl, a bespoke work for Objects With Narratives?
This is a really emotional piece because it was based on the first drawing that I made when I started this project. It was the piece the made it all come together. While working in fashion, you of course have to draw things technically, and understandably, how the models actually look like but I really missed drawing people the way I feel about them. So the drawing of this piece is based on friendship and shows the spirits and angels that surrounds us for everything that is important.
If you have a friendship, you can go into this world forever, So the way both of the figures hold each others makes them both weightless. That is the same to me with love and beauty, the more you create, the more there is. Then for me this piece really is a longing to make something physical out of those emotions.

What were some key influencing factors that made you transition to collectible design?
It really was kind of a spiral. Of course, it has been very inspired by the Anthroposophic way of living from attending a school with the Steiner method for the full 12 years, but also one of the things I really love about this education is that they encourage you to stay a child for as long as possible.
While you are encouraged to learn and to develop your brain as much as possible, you are also encouraged to keep playing—and I think that is such an important part of life because the more you can keep playing and mixing that with curiosity, you can still learn. The difference is you learn without even knowing you are learning anymore. I think it is such a beautiful way of teaching, in which you encourage the discovery and curiosity rather than having set rules to learn.
Normally in the traditional school system, as a child you are always taught in more of a university way. However for me, instead of having textbooks, I would listen to somebody talk, and then be encouraged to discuss it with peers. In the beginning you just make drawings, and then eventually you make your own text. You make your own textbooks from it, and once you've had the discussions about it—and maybe your your own texts and drawings— you suddenly don't need to study it anymore because you know it. This is something I have been really trying to keep it for the rest of my life as well. That is also what inspired my style and I think a lot of people would describe my style as naïve but this actually comes from a natural intuition and curiosity to explore what is going to happen when you create in a certain way.
At the beginning I went into fashion because it was a way of expressing myself as a quiet child. I learned easily how much you can express just with visual output. So it was really interesting how when you put different clothes on, people treat you differently or you can get into a completely different mood, like you can spread and communicate a lot with just a visual.
Fashion is also a very fast paced and creative industry. Therefore I was also very intrigued by the idea of having to predict future trends. In fashion you work a year and a half in advance, thus you always have to think about what is going on in the world and keep questioning what will happen next. You are always engaged with the future and I believe that is also something that has always been part of me. When I started this new journey of creating these fuzzy pieces, was when the values of my early education all kind of came back to me.
How has the fashion industry influenced your choice of working predominantly with textiles and handwoven art forms?
When I started this project, the techniques really came from working in textiles at Viktor&Rolf. I remember for one project, the designers came up with this amazing idea to make red carpet dresses made out of carpet and so the red dresses were made out of ready made carpet. Then throughout the research process, the atelier found a few of the tools that then been lying around in the studio for a long time and I thought “Oh, I just really, really wanna try it and see what we can do with it!” The techniques are sort of complimentary and the materials have similar properties. It thus made sense to go in this direction.
Somehow, I do think textiles really work with my philosophy of making things because different from other materials, in which if it breaks you most likely have to start from scratch—for example, with ceramics sometimes it breaks in the oven—textiles has a very forgiving quality that you can always repair it. You can fix it, you can work around it , and I really love that because it reminds me of being human and being flawed.
We all go through traumas. We all go through difficult times and we do not throw away a human being because they have a scratch or a break, but we build ourselves around it and sometimes we become stronger because of what we built around what happened. Then you see the pieces history told through its layers that were made into something new instead of thrown away.

How would you say your work responds to the current moment and how does it anticipate to the next ?
I can never escape what is happening around me. I am very oversensitive person in general. This can be very difficult for me, but it can be a positive thing throughout the creation because everything that happens to you and around you becomes part of your work. So whatever happens in the world always does influence a lot.
I think in the past three months, there are for sure new influences that have impacted my work—mostly personal. My father just passed away a couple of months ago in a very beautiful way, and that really influenced my work by thinking about how life passes on. A lot of my work has incorporated this feeling that as humans we are only here for a short time—and it is a gift! Make the most of it and try to leave behind the most beautiful world for future generations to find.
There is something I have worked on this quite a lot in my work as well, which is how in the beginning and at the end of your life you just seem to open up in a completely different way. I feel that happens so much with children and the elderly, where they have this special connection to nature that is often forgotten in the middle of our life. However, this strong connection to the natural world is often present in the form of animism. I think that especially with children, you see it so much.
I think due to the overconsumption culture we live in, it is often taught that things should be disposable and that materials are just objects to make our lives easier. So if you can bring that feeling back of giving everything around you a personality and a soul, you get a little bit closer to nature you have in the beginning of your life.

If you could create the ideal space to live in, what would that look like?
Somehow in my mind with every piece I am weaving, they become a part of this universe that I would like us to go towards—and it is a bit of my own utopia, where I hope that as technology develops, so does the possibility of making my ideas a reality.
I hope that in the future we will not be able (or need to) build things by killing our natural resources and turning them into something they are not. Instead, I hope that we can work together with nature so that most things can be grown and cultivated rather than built from scratch.
The pieces I am currently working on, aim to convey this symbiosis. In my mind I imagine a utopia where you can pick your fruits growing just in your kitchen or having the weather seasons conveyed inside your house. So what if you can grow little clouds in your living room and they can become your couch? Then I think my dream living space is having the dream I create within my pieces to one day be conveyed in a future reality.
Considering your main use of material is leftover wool from textiles factories in the Netherlands, India, and Nepal what would you say is your personal connection to these countries?
I moved to the Netherlands first for a job in fashion and then fell in love with Amsterdam. It really is a great place to live and is open-minded when it comes to innovation and creativity. The country also used to have a really big textile industry. When I just started making these pieces, I needed a lot of material which did not feel right to buy new ones. I found someone who was collecting leftovers from fabrics and was buying it from him. Afterwards he told me how the industry had moved abroad and he had been buying up the leftovers from when the factories closed down. The search for new sustainable materials was a journey to follow the traces that the textiles industry left behind. That is when I found this UNESCO Heritage site, which is where I now source leftover wool from.
Everything they make is handmade and preserve a lot of old techniques rather than to just mass produce. It was also a question of quality and knowing that there was no child labor. After working with this family to source wool, they eventually asked if they could also be involved in weaving the pieces. Something I was doing it alone in the studio but as we have been growing together with OWN and had more orders coming in, we started collaborating with them. I would show how we were doing things here and based on the tools they had available, we worked to find the best way to combine the techniques.


Do you have any new projects that you are working on?
We just started making a piece from all our own off-cuts. We have thus been experimenting with the leftovers of the leftovers... This creates beautiful textures done completely without any glues or any stretches. It is created using this traditional tool, consisting of little needles with scales so when you push the textile through the felt base, you lock them in together.

Do you have a dream project?
I've always really dreamed about making a full landscape of fuzzy pieces: the full floor, furniture, walls and ceiling. A space to see what that world that I have in my head would look and feel like if it was completely covered. For exaple the ceiling to have a few things hanging that you get a feeling of being in a forest. Or having the walls and floor covered would give you the liberty to feel the textures, lay down and roll around it. To see that in reality would be really a dream for me, so hopefully one day!